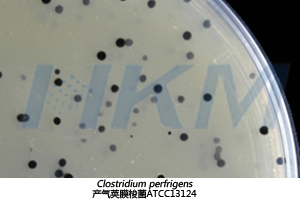
产气荚膜梭菌在SPS琼脂培养基上生长特征 产气荚膜梭菌在SPS琼脂培养基上生长特征

相关产品推荐更多 >
万千商家帮你免费找货
0 人在求购买到急需产品
- 详细信息
- 文献和实验
- 技术资料
- 库存:
99999
- 英文名:
Sulfite Polymixin Sulphadiazine Agar
- 保质期:
贮存期三年
- 供应商:
广东环凯官方厂家
- 保存条件:
贮存于避光、干燥处,用后立即旋紧瓶盖
- 规格:
250g/瓶
产品名称:亚硫酸盐-多粘菌素-磺胺嘧啶(SPS)琼脂培养基
英文名称:Sulfite Polymixin Sulphadiazine Agar
其它叫法:SPS琼脂基础培养基
产品编号与包装规格:
| 产品编号 | 产品类型 | 包装规格 |
| 028031 | 干粉 | 250g/瓶 |
产品用途:用于生活饮用水中产气荚膜梭菌的分离培养和计数。
SPS琼脂培养基检验原理:胰酪胨和酵母膏粉提供碳氮源、维生素和生长因子;亚硫酸钠和柠檬酸铁铵用于检测硫-化-氢的产生,使菌落中心呈黑色;琼脂是培养基的凝固剂;多粘菌素 B 和磺胺嘧啶钠抑制非梭菌的细菌生长。

配方成分:
| 配方(每升) | 含量 |
| 胰酪胨 | 15.0g |
| 酵母膏粉 | 10.0g |
| 柠檬酸铁铵 | 1.0g |
| 琼脂 | 15.0g |
| 最终pH 7.0±0.2 | |
使用方法:称取本品干粉 41.0 g,加入蒸馏水或去离子水 1000 mL,搅拌加热煮沸至完全溶解,分装三角瓶,每 瓶 250 mL ,121℃高压灭菌 15 min。待 SPS 培养基冷至 50℃左右,每 100 mL 培养基基础加入配套试剂 2 支(SR0150)(试剂 a:,亚硫酸钠 100 mg 和试剂 b:磺胺嘧啶钠 12 mg 和多粘菌素 B1.2 mg),摇匀倾注无菌平板。
SPS琼脂培养基质量控制(下列质控菌株接种后于35~37℃厌氧培养24h,观察结果如下表:)
| 指标 | 质控菌株及编号 | 标准值 | 特征性反应 |
| 生长率 | 产气荚膜梭菌ATCC13124 | PR≥0.7 | 黑色菌落 |
| 选择性 | 艰难梭菌ATCC43592 | G≤1 | — |
| 特异性 | 金葡菌ATCC6538 | — | 无色菌落 |
储存条件与保质期:贮存于避光、干燥处,用后立即旋紧瓶盖;贮存期三年。
参考文献:GB/T 5750-2023 中华人民共和国国家标准 生活饮用水标准检验方法

广东环凯微生物科技有限公司是广东省微生物研究所(隶属广东省科学院)属下的国家高新技术企业。
“专注微生物监测控制,为食药安全保驾护航”是环凯的使命。自1993年成立以来,环凯坚持科技创新发展战略,形成了具有自主知识产权的微生物检测试剂、微生物检测配套产品及耗材等系列产品线,逾两千个品种的产品,广泛应用于世界各地。环凯现已发展为国内食品、药品安全监测与控制技术和产品的重要研发生产基地,致力于为食品、医药行业提供全方位的微生物安全解决方案。
环凯依托广东省微生物研究所及自身优势,具备较强的研发实力,拥有与国际先进水平接轨的良好科研条件,建有广东省食品微生物安全工程技术研究开发中心。公司创始人兼首席科学家吴清平院士,长期从事生物安全监测与控制以及微生物发酵工程等领域的研究工作。在创新成果上,公司取得国家科学技术奖2项、省部市级科学技术奖励11项、中国优秀专利奖2项;申请专利150余项,获得授权专利92项,其中发明专利60项;在国内外学术期刊发表论文逾200篇。同时,环凯积极承担国家标准及行业标准制订工作,主导制定了《培养基质量控制标准GB4789.28-2013》,参与制定了饮用天然矿泉水、包装饮用水微生物国家标准。

风险提示:丁香通仅作为第三方平台,为商家信息发布提供平台空间。用户咨询产品时请注意保护个人信息及财产安全,合理判断,谨慎选购商品,商家和用户对交易行为负责。对于医疗器械类产品,请先查证核实企业经营资质和医疗器械产品注册证情况。
文献和实验参考文献:GB/T 5750-2023 中华人民共和国国家标准 生活饮用水标准检验方法
参考文献:GB/T 5750-2023 中华人民共和国国家标准 生活饮用水标准检验方法
参考文献:GB/T 5750-2023 中华人民共和国国家标准 生活饮用水标准检验方法
技术资料









